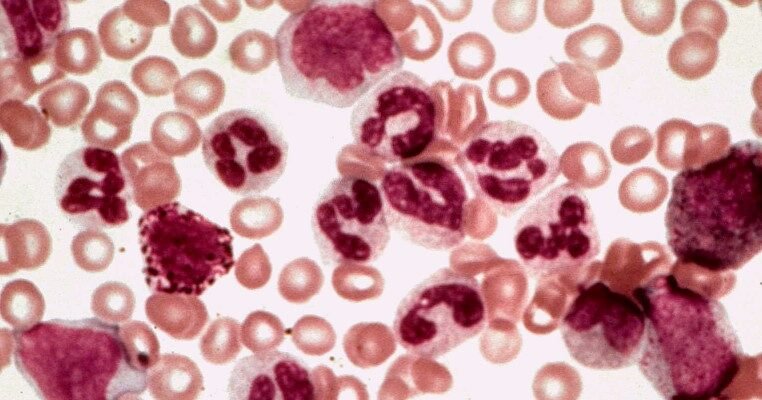
Лейкемія: Причини, симптоми та сучасні методи лікування хвороби

Зміст
Лейкемія: Що це таке?
Лейкемія, вона ж рак крові, — це така штука , яка може застати кого завгодно зненацька. Уявіть собі — ваші лейкоцити, ці дрібні бійці з інфекціями, раптом починають бунт. Вони розмножуються так, наче отримали фальшиву тисячу доларів. А здорові клітини просто не мають шансів.
Багатолика лейкемія
- Гостра лейкемія: Як блискавка серед ночі — миттєва і жахаюча. Лікування потрібне вже вчора.
- Хронічна лейкемія: Інша справа, коли хвороба розвивається ніби настільна гра довжиною в життя.
- Лімфобластна лейкемія: Вражає «поліцейських» нашого тіла — лімфоцити. Вони стояли на варті, але потім…
- Мієлоїдна лейкемія: Захворювання, яке атакує мієлоїдні клітини. А ті, у свою чергу, відповідальні за оборону проти мікроорганізмів.
Коли тіло сигналізує: Симптоми
- Втома та слабкість: Немов після марафону, а пробігли лише до кухні.
- Синяки та кровотечі: Раптові, як несподіваний дощ.
- Підвищення температури: ️ Намагається сказати, що щось не так, але що саме?
- Збільшення лімфатичних вузлів: Як балконні квіти, але хотілося б без них.
- Біль у кістках та суглобах: Відлуння з кісткового мозку.
- Втрата апетиту та схуднення: Коли їжа більше не вабить.
Що ж на нас впливає: Фактори ризику
- Вік: З кожним днем шанси ніби наближаються до нерозкритої карти.
- Генетика: Якийсь невдалий жарт природи?
- Вплив випромінювання: Невидиме вороже поле. Навіть при звичних рентгенах.
- Хімічні речовини: Контакт з бензолом — чісельник в рівнянні хвороби.
- Вірусні інфекції: Той підступний вірус Епштейна-Барр, що жартує з імунітетом.
Діагностика: Як дізнатися, чи є проблема
- Аналіз крові: Скаже більше, ніж ти подумав би.
- Аспірація та біопсія кісткового мозку: Розгляд під мікроскопом — як відкрити книгу з маленькими монстрами всередині.
- Молекулярні тести: Допомагають зрозуміти, що за тип лейкемії ми маємо та яким буде майбутнє.
Боротьба з ворогом: Лікування
- Хіміотерапія: Як розігріти вогонь на холоді. Це може бути страшно.
- Променева терапія: Любов до Світла, але в иншому сенсі.
- Таргетна терапія: Точно, як стріла робіна гуда.
- Пересадка стовбурових клітин: О, як це нове життя, яке чекає на нас.
Прогноз: Хмари на горизонті або ні?
Чесно кажучи, все залежить від безлічі речей. Тип, вік, навіть, коли ти щасливчик. У когось вона виліковується, не залишаючи сліду. У інших — це боротьба довжиною в життя. Але сучасні можливості дають все більше шансів для перемоги.
Лейкемія — це серйозно. Але хай там що, підтримка сім’ї та друзів, а також чудова медична допомога можуть змінити все. Крок за кроком, день за днем.
“`